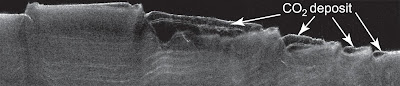

NEWS SPAZIO :- Sepolta sotto la superficie del Polo Sud di Marte vi è una enorme quantità di ghiaccio secco (anidride carbonica allo stato solido), 30 volte superiore rispetto a quanto si ritenesse in passato.
Questa eccezionale scoperta è stata realizzata con i dati acquisiti dalla sonda NASA Mars Reconnaissance Orbiter (MRO), in particolare dallo strumento SHARAD (Shallow Subsurface Radar, radar a penetrazione nel sottosuolo), fornito dall'Agenzia Spaziale Italiana e le cui operazioni sono guidate dal Dipartimento INFOCOM dell'Università La Sapienza di Roma.
Già in precedenza SHARAD aveva identificato enormi quantità di ghiaccio d'acqua su Marte ed altrettanto enormi quantità di acqua purissima nel suo Polo Nord.
Ma questa volta parliamo di CO2, anidride carbonica congelata scovata dagli eco radar di SHARAD per una quantità totale - impressionante - pari a 10.000 chilometri cubici. La scoperta è pubblicata in un articolo pubblicato il 21 Aprile dalla rivista Science.
"Sapevamo già che c'è una piccola calotta perenne di ghiaccio di CO2 in cima al ghiaccio d'acqua, ma questo deposito 'sepolto' in profondità ha circa 30 vole più ghiaccio di CO2 di quanto stimato in precedenza" sono le parole di Roger Phillips (Southwest Research Institute di Boulder, Colorado) vice team leader per lo strumento SHARAD ed autore principale della pubblicazione.
"Abbiamo identificato il deposito come ghiaccio secco verificando che la firma radar corrisponde molto meglio a quella del CO2 ghiacciato piuttosto che a quella dell'acqua ghiacciata" ha dichiarato Roberto Seu (Università La Sapienza di Roma), team leader di SHARAD e co-autore della pubblicazione.
La cosa importante per gli scienziati è che la quantità individuata di ghiaccio di CO2 è tale da avere la potenzialità di variare il clima di Marte. Vediamo come.
Il pianeta Marte ha attualmente un'inclinazione del proprio asse di circa 25°, un po' come la nostra Terra. Ma a differenza di quest'ultima il Pianeta Rosso non ha una luna grande abbastanza da stabilizzarlo. Ne risulta una variazione ciclica della sua inclinazione, da 10° a più di 40° (naturalmente su lunghi periodi temporali).
Quando l'inclinazione è massima i Poli assorbono maggiore radiazione solare in estate e quindi una maggior quantità di calotta polare di CO2 vaporizza nell'atmosfera (composta al 95% di CO2). Quando invece l'inclinazione è al minimo ed i Poli sono maggiormente in ombra accade l'opposto. Attualmente sembra che ci troviamo a metà di un ciclo, con metà CO2 in gas nell'atmosfera e l'altra metà congelata nel Polo Sud.
Un aumento del gas nell'atmosfera potrebbe portare a fenomeni molto particolari, tra cui venti più forti i quali a loro volta solleverebbero maggiore polvere portando a più frequenti e più intense tempeste di sabbia.
Una aumento della densità dell'atmosfera (e quindi della pressione atmosferica) potrebbe rendere più facile avere aree sulla superficie in grado di consentire la presenza di acqua liquida (senza che questa vada in ebollizione).
Vari modelli basati sui nuovi dati indicano che una variazione significativa dell'atmosfera marziana potrebbe avvenire in circa 100.000 anni (o anche meno).
Le parole di Robert Haberle (planetary scientist centro NASA Ames Research Center di Moffett Field, California) co-autore: "Un Marte più inclinato con un'atmofera più spessa di CO2 genera un effetto serra che cerca di riscaldare la superficie Marziana, di contro ad un più spesso strato di ghiaccio polare che cerca di raffreddarla. Le nostre simulazioni mostrano che le calotte polari raffreddano più di quanto riesca a scaldare l'effetto serra. A differenza della Terra, la quale ha un'atmosfera spessa ed umida che produce un forte effetto serra, l'atmosfera di Marte è troppo sottile e secca per produrre un effetto serra simile, anche se la quantità di CO2 fosse doppia".
Insomma, ecco un nuovo tassello per meglio comprendere i misteri del Pianeta Marte.
Immagini, credit NASA/JPL-Caltech/Università La Sapienza di Roma/Southwest Research Institute.
Fonte dati, NASA, Scientific American.

Nessun commento:
Posta un commento
Chiunque può liberamente commentare e condividere il proprio pensiero. La sola condizione è voler contribuire alla discussione con un approccio costruttivo e rispettoso verso tutti. Evitate di andare off-topic e niente pubblicità, grazie.